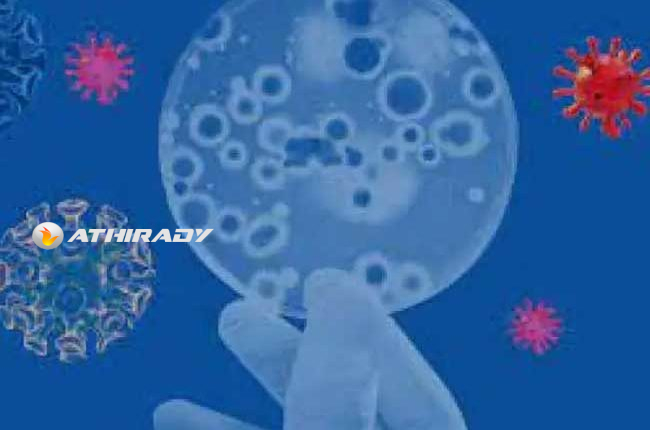

கர்ப்பிணித் தாய்மார்களுக்கிடையில் வேகமாக பரவும் இன்புளுவன்சா வைரஸ்!!
தற்போது வேகமாகப் பரவி வரும் இன்புளுவன்சா வைரஸ், கர்ப்பிணித் தாய்மார்களுக்கும், குழந்தை பிரசவித்த தாய்மார்களுக்கும், குழந்தைகளுக்கும் கடுமையான பாதிப்புகளை ஏற்படுத்தும் என்பதனால் மிகவும் அவதானமாக இருக்குமாறு வலியுறுத்தப்பட்டுள்ளது.
மகப்பேற்று மற்றும் மகளிர் மருத்துவ நிபுணர் சனத் லெனாரோல் இவ்வாறு வலியுறுத்தியுள்ளார்.
கர்ப்பிணித் தாய்மார்கள் முடிந்தவரை முகக் கவசம் அணியுமாறும், வைரஸ் பரவுவதைத் தவிர்ப்பதற்காக மேலும் மக்கள் நெரிசல் மிகுந்த இடங்களுக்கு செல்வதை தவிர்க்க வேண்டும் எனவும் அவர் கோரியுள்ளார்.
இந்த நாட்களில் காய்ச்சல் ஏற்படுமிடத்து உடனடியாக மகப்பேற்று மற்றும் மகளிர் மருத்துவ நிபுணரை சந்தித்து மருத்துவமனையில் அனுமதிக்கவும். தாயும் குழந்தையும் கூடிய விரைவில் மருத்துவமனையில் அனுமதிக்கப்பட்டால், அவர்களுக்கு ஏற்படும் பாதிப்புகளில் இருந்து பாதுகாக்க தேவையான சிகிச்சை அளிக்க முடியும் எனவும் அவர் மேலும் குறிப்பிட்டுள்ளார்.
“அதிரடி” இணையத்துக்காக தென்னிலங்கையில் இருந்து “எல்லாளன்”


